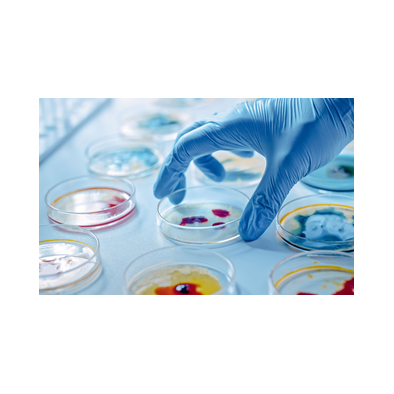

Products
- Pharmaceutical Products Testing
- Food Products Testing
- Water and Energy Drink Products Testing
- Honey Testing
- Cosmetic Products and Personal Care Products Testing
- Perfume and Perfumery Product Testing
- Detergent and Disinfectant Testing
- Food Contact Material Testing
- Biodegradability Testing for Plastics, Detergents, and Cosmetics
- Environmental Testing